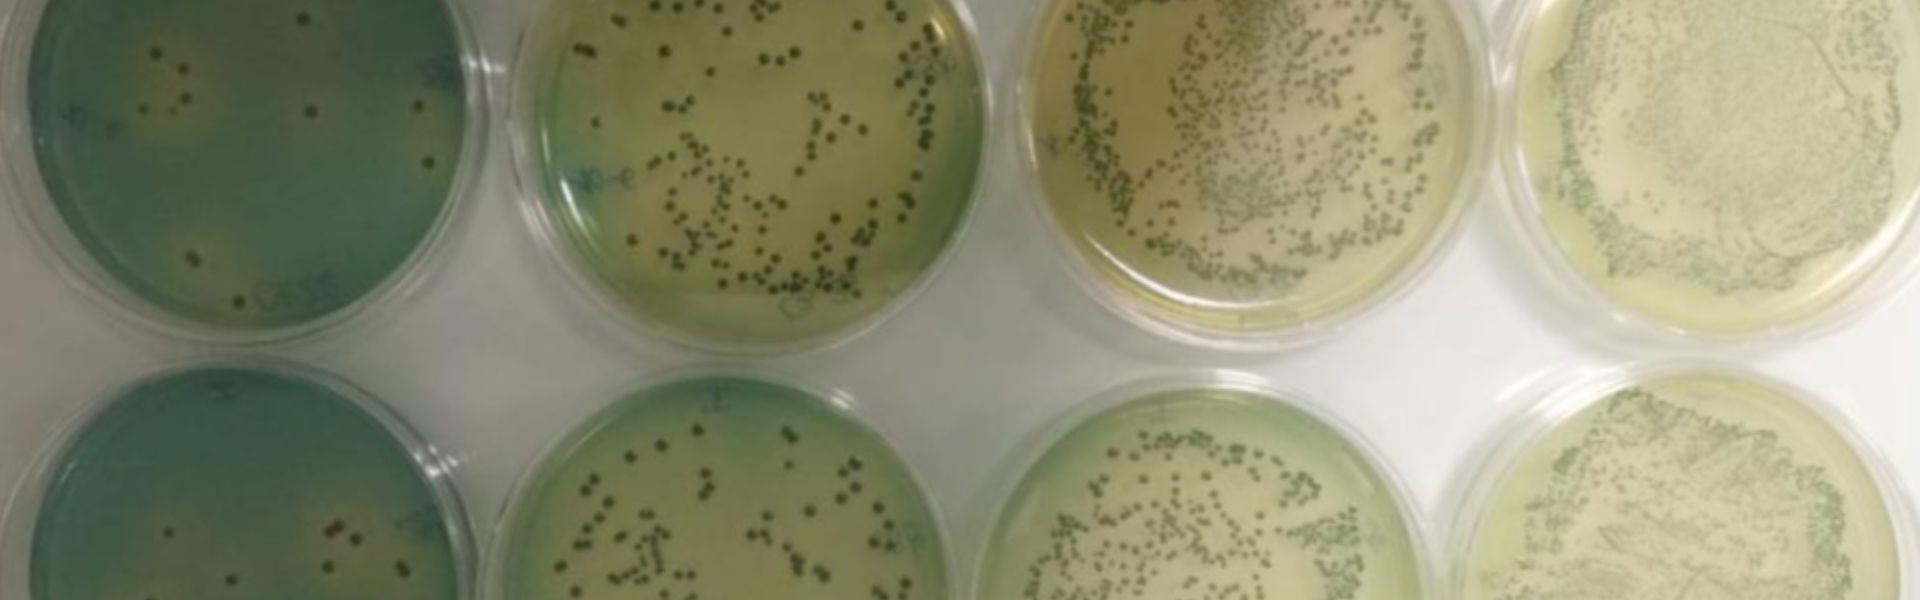

Joeplast guida l’innovazione con un nuovo packaging compostabile

Il progetto BioTrak si propone di definire un sistema innovativo per la tracciabilità delle filiere zootecniche bovine grazie al riutilizzo della sansa d'oliva

In Sicilia un progetto ambizioso: pensare e costruire strumenti per contrastare la disinformazione online, sempre più pervasiva.

L’edificio ospita il Plesso Garibaldi della scuola “Rapisardi-Garibaldi”

Soluzioni innovative per le officine meccatroniche

La centrale Terna realizzata per migliorare performance, sicurezza e affidabilità della rete elettrica

OMER S.p.a. opera a livello internazionale nel settore della componentistica ferroviaria sostenibile, destinata all’allestimento di treni ad alta velocità, regionali e metropolitane.


Il progetto Sì-Mare punta all’innovazione nel campo dei materiali per la cantieristica navale con l’obiettivo di alleggerire le imbarcazioni e ridurre i consumi
Uno studio per l’impiego nel settore enologico di ceppi di lievito “non-Saccharomyces” che consentono di migliorare la qualità del vino

Definizione, progettazione e realizzazione, all’interno del Campus dell’Università degli Studi di Palermo, di un dimostratore di parcheggio di nuova concezione.

A Marsala un centro aggregativo polivalente che promuove l’inclusione sociale attraverso lo sport

Trasporti più moderni con i convogli ferroviari di ultima generazione acquistati dalla Regione con i fondi Ue

In Sicilia si potenzia la ricerca: a Palermo un centro all'avanguardia con servizi di diagnostica sempre più avanzati e approcci clinici personalizzati per la medicina di precisione

Circumetnea: da piazza Stesicoro all'aeroporto, un percorso lungo 6,8 chilometri interamente in galleria con la costruzione di otto nuove stazioni ferroviarie

In Sicilia nasce Idmar, un’infrastruttura di ricerca con cinque poli e un telescopio a 3mila e 500 metri di profondità. Per monitorare il mare in tempo reale, una novità assoluta nel Mediterraneo

Quattordici moduli USAR per tutto il territorio siciliano, con attrezzature specialistiche per la ricerca e il salvataggio dei dispersi

MELCAL, una giovane azienda del Trapanese, potenzia la produzione di mezzi di sollevamento destinati al settore marino e alle aree portuali di tutto il mondo

L’intervento coinvolge oltre 250 comuni e due milioni di cittadini, per portare la connessione ad alta velocità anche nelle zone in cui gli operatori privati non investono, le cosiddette aree bianche
#EuropeLoveSicily non è soltanto uno slogan. È un percorso di comunicazione, una bandiera, un hashtag: è attuale, al passo coi tempi, amato dai giovani e, proprio per questo, veicolo di grande modernità. #EuropeLoveSicily viaggia sui nuovi treni Pop che sfrecciano nell’Isola, attraversa città, campagne e passaggi a livello, ed entra nei cuori dei siciliani. Oggi è anche uno spazio web dedicato a tutti i cittadini, per raccontare le storie più belle che la Regione Siciliana scrive con i fondi europei.
Il progetto di recupero dell’Ex-Albergo Scuola di Siracusa ha previsto la completa ristrutturazione dei locali attraverso l’adeguamento sismico delle strutture, la riprogettazione delle ...
Leggi la storiaIl progetto Bioclearpack ha avuto come obiettivo principale lo studio e la produzione di polimeri biodegradabili e/o compostabili in grado di sostituire i materiali polimerici tradizionali, ...
Leggi la storiaIl progetto BioTrak si propone di definire un sistema innovativo per la tracciabilità e certificazione di due filiere zootecniche bovine, quella del latte e quella della carne, basate sull...
Leggi la storiaIl progetto, inequivocabile già dal nome, ha messo insieme una rete di attori pubblici e privati, con l’obiettivo condiviso di tutelare e monitorare la qualità e la trasparenza dell’in...
Leggi la storiaVilla Gallidoro è un edificio di stile neorinascimentale di fine '800, alla cui decorazione (compresi i camini monumentali), ha preso parte anche l’architetto Ernesto Basile, sorge in un ...
Leggi la storiaCon il progetto cofinanziato con le risorse del Po Fesr Sicilia 2014-20 Magicmotorsport ha mirato ad ampliare la gamma di prodotti realizzando proposte innovative rivolte all'utente finale (...
Leggi la storiaModernizzazione e sviluppo del sistema elettrico regionale: il progetto Nuova Stazione Elettrica 380/150 kV di Vizzini con raccordi aerei 380-150 kV alla Rete di Trasmissione Nazionale conse...
Leggi la storiaIl progetto I-Sole - Smart Grids per le Isole Minori si propone di sviluppare soluzioni tecniche innovative, a basso costo e di semplice installazione, per il monitoraggio, il controllo dell...
Leggi la storiaL’intervento si inquadra nel progetto di chiusura dell’anello ferroviario di Palermo, che prevede il prolungamento della tratta esistente e funzionante tra Notarbartolo e Giachery che ve...
Leggi la storia